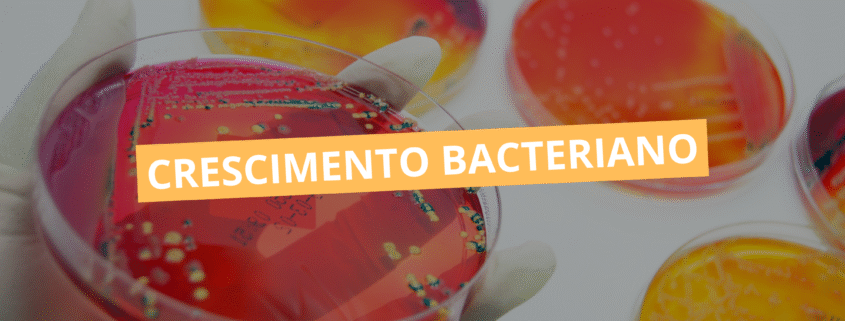

Crescimento bacteriano
O crescimento bacteriano constitui um dos eixos centrais da microbiologia, e seu entendimento é essencial para interpretar processos infecciosos, desenvolver fármacos, aperfeiçoar técnicas laboratoriais e compreender ecossistemas microbianos. Embora seja frequentemente descrito apenas como o aumento do número de células, o crescimento é, na realidade, um fenômeno complexo que envolve coordenação genética, regulação metabólica, capacidade adaptativa e interação com o ambiente. Compreender esse processo em profundidade permite prever comportamentos populacionais, interpretar resultados laboratoriais e reconhecer padrões que influenciam tanto a saúde humana quanto aplicações biotecnológicas.
Mecanismos fundamentais
O crescimento bacteriano corresponde ao aumento da biomassa e da população microbiana, resultante principalmente da divisão binária, um processo altamente ordenado que garante a duplicação cromossômica e a formação de duas células-filhas. A divisão binária não é apenas um evento mecânico, mas um processo integrado em que a célula precisa acumular energia, nutrientes e componentes estruturais, além de coordenar uma série de mecanismos moleculares. A replicação do DNA, por exemplo, é iniciada em uma região específica do cromossomo, a oriC, e progride de maneira bidirecional; simultaneamente, a célula reorganiza sua estrutura interna, produz ribossomos, proteínas de parede e elementos de membrana que permitirão a formação do septo.
A citocinese envolve o recrutamento de proteínas do sistema Fts, especialmente a FtsZ, que organiza o anel zintal e estabelece o ponto exato de divisão. Esse processo depende de verificações internas complexas, as chamadas checkpoints bacterianas, que asseguram que a replicação cromossômica esteja concluída ou suficientemente adiantada para evitar danos genéticos nas células filhas. O resultado final é a geração de duas células metabolicamente competentes, cuja velocidade de formação é expressa no chamado tempo de geração, parâmetro variável de acordo com a espécie e com as condições ambientais
Curva de crescimento bacteriano
A dinâmica do crescimento bacteriano em sistemas fechados, como cultivos em laboratório, pode ser representada pela clássica curva de crescimento, dividida em quatro fases, cada uma caracterizada por comportamentos fisiológicos específicos.
Fase lag
Durante a fase lag não há aumento mensurável no número de células, mas a cultura passa por um período de adaptação ativa. As bactérias sintetizam enzimas necessárias para utilizar os nutrientes disponíveis, reorganizam suas vias metabólicas, ajustam o pH intracelular e reparam possíveis danos resultantes de condições anteriores. Trata-se de uma fase essencial para assegurar que as células estejam fisiologicamente aptas a iniciar a divisão, e sua duração varia conforme o estado inicial da cultura e a natureza do meio.
Fase log ou exponencial
Na fase log, a população bacteriana cresce a uma taxa constante e máxima, resultando em duplicações regulares e previsíveis. As células apresentam intenso metabolismo, expressão gênica otimizada para proliferação, e baixa variabilidade fisiológica. Essa fase é de extremo interesse biotecnológico e clínico, pois nela as bactérias mostram maior sensibilidade a antibióticos que atuam sobre vias de síntese ativa, como β-lactâmicos. Além disso, seu comportamento matemático permite modelagens precisas para análises industriais e pesquisas experimentais.
Fase estacionária
Com a progressão do cultivo, os nutrientes tornam-se limitados e metabólitos tóxicos acumulam-se, levando ao equilíbrio entre crescimento e morte celular. Embora a população total permaneça relativamente constante, ocorrem mudanças fisiológicas profundas: ativação de genes de estresse, síntese de pigmentos, produção de esporos e formação de biofilmes. Muitas bactérias passam para um estado metabólico reduzido, aumentando sua resistência a condições adversas, inclusive a antimicrobianos.
Fase de morte
Por fim, na fase de declínio, a taxa de morte supera a taxa de divisão. A integridade da membrana é comprometida, ocorre perda de capacidade metabólica e lise celular progressiva. Ainda assim, parte da população pode persistir em estados metabólicos mínimos, contribuindo para fenômenos como tolerância, persistência e recrescimento após tratamentos antimicrobianos.
Fatores que regulam o crescimento bacteriano
O desempenho das populações bacterianas depende de fatores ambientais e fisiológicos que modulam a sobrevivência, o metabolismo e a taxa de divisão. Entre esses fatores, a temperatura é um dos mais determinantes, pois afeta diretamente a fluidez da membrana, a atividade enzimática e a estabilidade de proteínas estruturais. As bactérias distribuem-se em faixas térmicas específicas, como psicrófilas, mesófilas e termófilas, cada qual adaptada a uma janela de estabilidade metabólica.
O pH exerce influência semelhante: alterações extremas podem desestabilizar proteínas, interferir em gradientes eletroquímicos e comprometer sistemas de transporte. O oxigênio, por sua vez, define diferentes estratégias metabólicas. Enquanto aeróbias estritas dependem de cadeias respiratórias completas, anaeróbias estritas sofrem danos letais por espécies reativas derivadas do oxigênio. Anaeróbias facultativas, microaerófilas e aerotolerantes ampliam esse espectro, ajustando vias fermentativas e respiratórias conforme a disponibilidade de oxigênio.
Outro elemento fundamental é a disponibilidade de nutrientes, especialmente carbono, nitrogênio e ferro, este último frequentemente limitado no hospedeiro, funcionando como mecanismo de defesa conhecido como “imunidade nutricional”. A água disponível e a pressão osmótica modulam a hidratação celular e influenciam a integridade da parede e da membrana, enquanto mecanismos de quorum sensing permitem que as bactérias coordenem sua densidade populacional, ajustando crescimento, virulência e formação de biofilmes.
Métodos de quantificação do crescimento
A avaliação do crescimento bacteriano é crucial tanto em microbiologia clínica quanto em pesquisas e bioprocessos. A contagem de unidades formadoras de colônia (UFC) é o método padrão para estimar células viáveis, já que considera somente aquelas capazes de gerar colônias visíveis. Métodos turbidimétricos, baseados na absorbância da cultura, permitem monitoramento rápido e não destrutivo, embora incluam células vivas e mortas. Técnicas microscópicas diretas oferecem contagens totais, mas exigem habilidade e apresentam limitações em precisão.
Métodos mais modernos, como citometria de fluxo e ensaios fluorimétricos, diferenciam células vivas, mortas e em estados intermediários com maior sensibilidade, tornando-se ferramentas poderosas para análises de populações complexas. Em ambientes industriais, parâmetros como consumo de oxigênio, produção de CO₂ e alterações de pH servem como indicadores indiretos do crescimento e da atividade metabólica.
Crescimento em biofilmes
Os biofilmes representam uma forma altamente organizada de crescimento bacteriano, em que células aderem a superfícies e produzem uma matriz extracelular que confere proteção mecânica e química. O crescimento em biofilme é heterogêneo: regiões externas apresentam maior atividade metabólica, enquanto camadas internas permanecem em estado quase quiescente. Essa diversidade confere resistência aumentada a antimicrobianos e ao sistema imune, sendo um desafio significativo em cateteres, próteses, feridas crônicas e ambientes hospitalares.
O crescimento bacteriano é um fenômeno dinâmico que integra aspectos genéticos, bioquímicos, fisiológicos e ambientais. Seu estudo fornece a base necessária para compreender desde a dinâmica das infecções até processos de biotecnologia, controle de qualidade, desenvolvimento de fármacos e manejo de surtos. Embora seja um conceito clássico da microbiologia, permanece atual devido à crescente importância de temas como resistência antimicrobiana, comportamento de biofilmes e modelagem de ecossistemas microbianos. Para estudantes e profissionais da saúde, dominar esse assunto é fundamental para interpretar fenômenos clínicos e laboratoriais com precisão e pensamento crítico.
Quer transformar seu conhecimento em prática real de laboratório? A Pós-graduação em Microbiologia Clínica da Cursau é o próximo passo para quem quer se destacar no diagnóstico microbiológico e na rotina clínica. INSCRVA-SE NA PÓS-GRADUAÇÃO EM MICROBIOLOGIA CLÍNICA